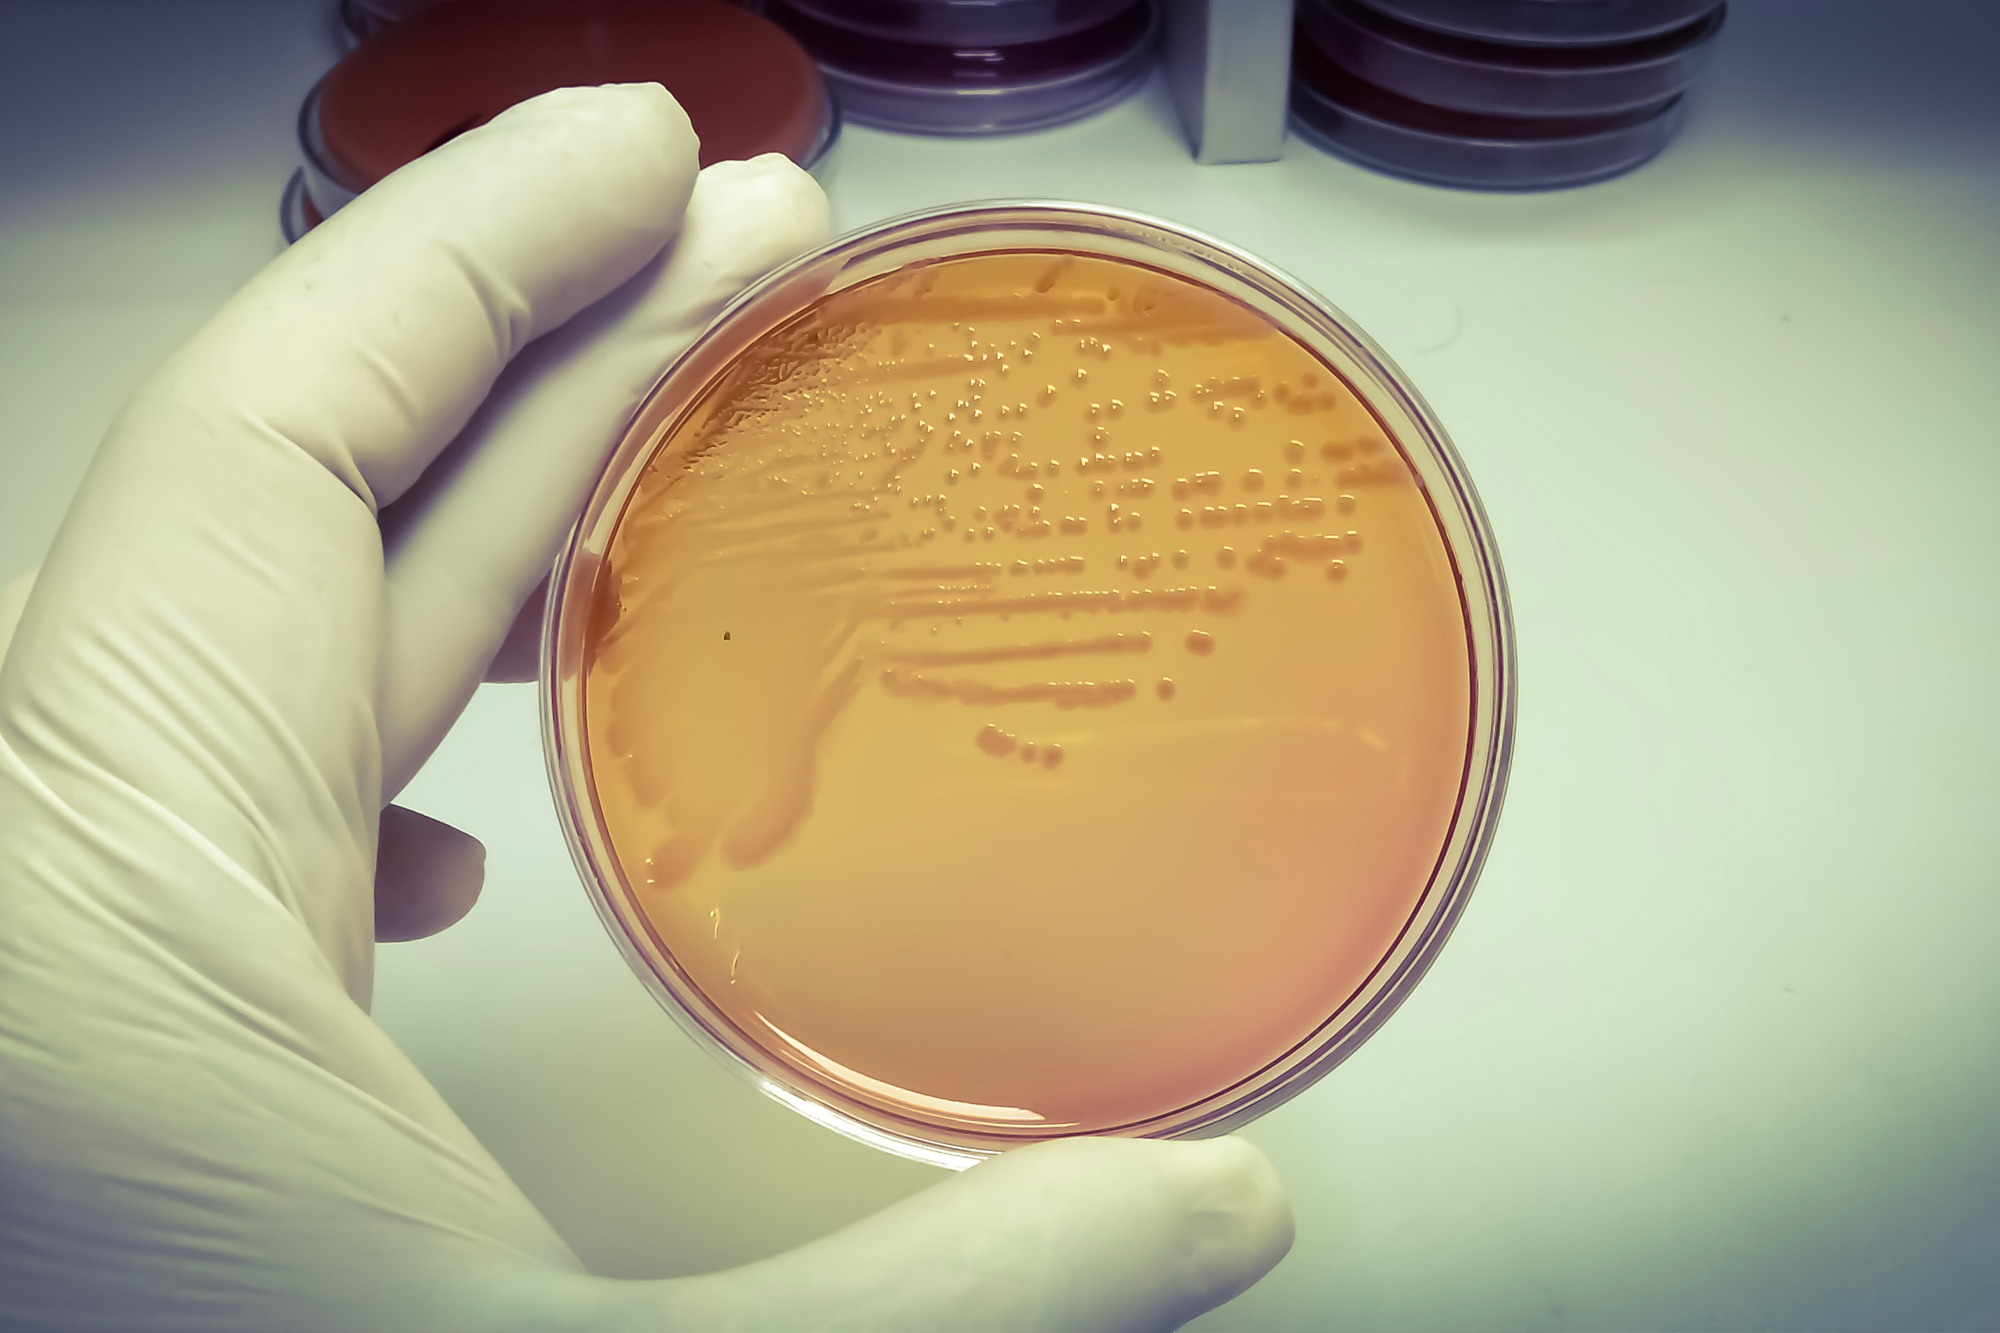
Nuôi cấy vi khuẩn là cách đáng tin cậy nhất để chẩn đoán nhiễm khuẩn salmonella. (Ảnh: Arif Biswas/Shutterstock)

Một số trường hợp tử vong gần đây có liên quan đến việc ăn một loại trái cây nhất định. Tuy nhiên, nguyên nhân tử vong có thể được tìm thấy trong các loại thực phẩm hàng ngày khác.
Vào ngày 12/11, Cơ quan Quản lý Thực phẩm và Dược phẩm Hoa Kỳ (FDA) đã ban hành lệnh thu hồi dưa vàng (cantaloupe) nhiễm salmonella. Ba trường hợp tử vong đã được công bố trong tháng qua, bên cạnh hàng trăm trường hợp gây ra bởi một trong những mầm bệnh ngộ độc thực phẩm nguy hiểm nhất ở Hoa Kỳ.
Kể từ khi phát hiện ra vi khuẩn salmonella cách đây gần 150 năm, con người đã cố gắng tiêu diệt loại vi khuẩn này nhưng không thành công.
Salmonella: Tại sao vi khuẩn này lại phổ biến trong thực phẩm?
Salmonella trông giống như một cái que nhỏ có đuôi dài, là nguyên nhân hàng đầu gây ra các ca nhập viện và tử vong do các bệnh do thực phẩm ở Hoa Kỳ mỗi năm.
Salmonella có thể được tìm thấy trong các thực phẩm như thịt, trứng, sữa, sản phẩm tươi sống và thậm chí cả thực phẩm chế biến sẵn.
Có hơn 2,500 biến thể của salmonella, nhưng không phải tất cả đều gây nhiễm trùng.
Nhiều động vật trang trại, đặc biệt là gia súc, lợn, và gà, có thể mang vi khuẩn salmonella một cách tự nhiên và không có biểu hiện bệnh. Điều này gây khó khăn cho việc loại bỏ hoàn toàn vi khuẩn khỏi thịt.
Ông Amilton de Mello, phó giáo sư về khoa học thịt và an toàn thực phẩm tại Đại học Nevada, nói với The Epoch Times: “Ví dụ, khi nhắc đến E. coli (Escherichia coli), chúng ta có một lượng đáng kể E. coli di chuyển bên trong cơ thể. Mặc dù một trong số E.coli có thể gây nhiễm trùng đường ruột đáng kể, nhưng phần lớn đều lành tính.” Một số vi khuẩn E. coli có thể gây nhiễm trùng đường ruột trầm trọng, nhưng nhiều loại là lành tính.

Hơn 25% gia cầm chứa vi khuẩn salmonella trong ruột. Năm 2019, hơn 40% số ca nhiễm khuẩn salmonella qua thực phẩm là từ thịt gà, thịt heo, thịt bò, hoặc gà tây.
Ông Aliyar Fouladkhah, phó giáo sư tại Khoa Khoa học Nông nghiệp và Môi trường tại Đại học tiểu bang Tennessee, cho biết: “Rất khó để loại bỏ mầm bệnh này khỏi chuỗi thức ăn. “Vẫn còn hơn một triệu người Mỹ nhiễm vi khuẩn này trong một năm.”
Sự phổ biến của vi khuẩn salmonella trong thịt đồng nghĩa với việc thực phẩm bị ô nhiễm được phép lưu hành trên thị trường.
Ông Craig Hedberg, giáo sư tại Đại học Minnesota và đồng giám đốc của Trung tâm Xuất sắc về An toàn Thực phẩm Tích hợp Minnesota, đã viết cho The Epoch Times qua thư điện tử: “Ở Hoa Kỳ, salmonella được xem là vi khuẩn tạp nhiễm trong thực phẩm ăn liền, nhưng không phải [trong] các sản phẩm động vật sống như thịt và gia cầm. Một số quốc gia đã cấm một số chủng salmonella.”
Bộ Nông nghiệp Hoa Kỳ (USDA) đề xuất tuyên bố salmonella là vi khuẩn tạp nhiễm trong các sản phẩm gia cầm sống tẩm bột và nhồi vào tháng 08/2022. Điều này có nghĩa là những loại thịt này sẽ chỉ được phép chứa rất ít salmonella. Hiện vẫn chưa rõ liệu đề xuất này có được thực hiện hay không.
Không giống như E. coli, được xác định là chỉ có bảy chủng gây nhiễm trùng từ thực phẩm, salmonella có nhiều chủng có thể gây bệnh hoặc không gây bệnh. Vì vậy, việc kiểm soát các chủng gây bệnh trở nên khó khăn hơn.
Tuy nhiên, USDA yêu cầu các nhà sản xuất phải kiểm tra thịt thường xuyên. Mỗi lần sẽ kiểm tra 52 phần thân gà, và các lô thịt chỉ được xem là chấp nhận được nếu nhiều nhất 13 mẫu chứa salmonella.
Trong khi việc sản xuất các sản phẩm thịt dành cho trường học không được phép nhiễm khuẩn salmonella, thì các sản phẩm khác bao gồm gia cầm nguyên con, các phần và sản phẩm [thịt] xay được phép nhiễm salmonella dao động trong khoảng từ 7% đến 25% đối với các lô từ 51 đến 56 mẫu.

Ô nhiễm sản phẩm tươi sống và chế biến
Không giống như virus, vi khuẩn có sức chịu đựng rất tốt và có thể tồn tại trên các bề mặt, trong đất, và trong nước trong thời gian dài hơn.

Các nghiên cứu đã chứng minh rằng vi khuẩn salmonella có thể tồn tại trong đất và nước hơn một năm. Sản phẩm tươi cũng có thể bị nhiễm bệnh khi tiếp xúc với nước hoặc đất bị ô nhiễm. Hơn một phần ba số ca nhiễm khuẩn salmonella là do rau hoặc trái cây gây ra.
Rửa sạch bằng nước có thể loại bỏ tới 90% vi khuẩn trên bề mặt. Tuy nhiên, đôi khi bên trong sản phẩm cũng có thể bị nhiễm khuẩn.
Ông Fouladkhah cho biết: “Giả sử chúng ta mua một ít dâu tây và một ít dưa vàng để mang về nhà, rửa sạch và ăn. Nếu vi khuẩn [ở bên trong], chúng ta sẽ bị phơi nhiễm với những mầm bệnh đó.”
Vậy làm thế nào mà vi khuẩn salmonella có thể xâm nhập vào trái cây và rau củ? Sự nhiễm khuẩn có thể xảy ra tại chỗ dập nát hoặc vết cắt trên bề mặt trái cây và rau củ, bao gồm táo, cà chua và rau xanh.
Ông Donald Schaffner, giáo sư nổi tiếng về khoa học thực phẩm tại Đại học Rutgers, đã viết cho The Epoch Times qua thư điện tử: “Có thể vi khuẩn sẽ sinh sôi nảy nở ở những chỗ bị hư.”
Ông Schaffner cho biết thêm, trong phòng thí nghiệm, vi khuẩn salmonella cũng đã được chứng minh là có khả năng xâm nhập vào các sản phẩm tươi, không bị hư hại. Tuy nhiên, trên thực tế thì việc này vẫn chưa rõ ở mức độ nào.
Thực phẩm đã qua chế biến như bơ đậu phộng và bột bánh quy cũng có thể bị nhiễm khuẩn trong quá trình chế biến.
Ông Schaffner viết: “Đậu phộng có thể bị nhiễm khuẩn trong quá trình sản xuất và nếu không được chế biến đúng cách, vi khuẩn vẫn còn trong bơ đậu phộng. Lúa mì có thể bị ô nhiễm trên đồng ruộng trước hoặc sau khi thu hoạch.” Đó là lý do vi khuẩn có thể tồn tại trong bột mì chưa nấu chín.
Thu hồi sản phẩm: Phương sách cuối cùng
Vì thực phẩm bị nhiễm khuẩn salmonella có thể gây bùng phát dịch nên việc thu hồi là giải pháp cuối cùng để hạn chế các ca nhiễm tiếp theo.
Giải trình tự bộ gene được sử dụng để theo dõi các ca bệnh cho phép các nhà dịch tễ học liên kết các ca bệnh và truy tìm nguồn lây nhiễm chung.
Ông Fouladkhah nói: “Giả sử tôi đang bị bệnh ở Nashville. Đôi khi, có người ở Colorado cũng bị bệnh tương tự. Trong một khoảng thời gian ngắn, [các nhà dịch tễ học] có thể liên kết chúng lại với nhau. Sau đó là truy tìm dấu vết tiếp xúc và phỏng vấn bệnh nhân để xác định loại thực phẩm nghi ngờ.”
Mỗi một trường hợp có mức độ khó khăn trong việc theo dõi sự bùng phát khác nhau.
Ông Fouladkhah cho biết: “[Nhiễm khuẩn từ] sản phẩm tươi sống có thể khó khăn hơn một chút so với sản phẩm thịt vì chỉ có một số cơ sở sản xuất thịt heo trong nước.”
Tùy thuộc vào sản phẩm và cách thức tiến hành công việc dịch tễ học, việc thu hồi có thể được thông báo nhanh chóng trong vài ngày hoặc lâu nhất là hàng tuần và hàng tháng. Tuy nhiên, đôi khi không thể tìm thấy nguồn ô nhiễm.

Câu hỏi hóc búa về thanh trùng
Ngoài thịt và nông sản, trứng còn là nguồn lây nhiễm salmonella chính khác, chiếm gần 7% các bệnh do thực phẩm.
Hoa Kỳ có các quy định khác nhau đối với vi khuẩn salmonella trong trứng, được xác định dựa trên việc trứng đã bóc vỏ hay đã bị nứt.
Trứng bóc vỏ vỏ không cần phải thanh trùng, trong khi việc thanh trùng là bắt buộc đối với trứng dùng trong thực phẩm chế biến sẵn. Các nghiên cứu ước tính rằng chỉ có 3% trứng bóc vỏ được tiệt trùng.
Hai cơ quan quản lý trứng có vỏ và trứng không có vỏ đều có hướng dẫn riêng.
USDA quy định về trứng còn vỏ, trong khi FDA quy định về trứng đã bóc vỏ.
Ông Fouladkhah cho biết các quy định phụ thuộc vào quy mô và khả năng của mỗi cơ quan.
Đối với các công ty thực phẩm có sản phẩm thuộc thẩm quyền của USDA, thanh tra USDA tại chỗ giúp bảo đảm thực phẩm được sản xuất theo các quy định.
Ông Fouladkhah nói: “Nếu thuộc thẩm quyền của FDA, các công ty sẽ ít bị kiểm tra thường xuyên hơn. Điều này một phần là do FDA giám sát số lượng hoạt động lớn hơn nhiều, do đó họ không có nhiều thanh tra viên để kiểm tra thường xuyên hơn.”
Điều trị hay không điều trị
Chẩn đoán và điều trị nhiễm khuẩn salmonella có thể gặp khó khăn vì các triệu chứng tương tự như trong các bệnh do thực phẩm khác và các bệnh về dạ dày.
Cách đáng tin cậy nhất để chẩn đoán nhiễm khuẩn salmonella là nuôi cấy phân, quá trình này có thể mất ít nhất hai hoặc ba ngày. Chỉ bằng cách nuôi cấy salmonella, bác sĩ mới có thể biết được bệnh nhân nhiễm loại huyết thanh nào và loại kháng sinh nào sẽ phù hợp.
Giải trình tự bộ gene nhanh hơn nhiều và có thể phát hiện vi khuẩn salmonella trong vòng vài giờ. Tuy nhiên, phương pháp này không thể phát hiện chính xác loại huyết thanh và do đó không giúp hướng dẫn điều trị.
Sau khi xác định được loại huyết thanh, bác sĩ phải quyết định xem bệnh nhân có nên điều trị bằng kháng sinh hay không.
Ở những người khỏe mạnh, nhiễm khuẩn salmonella thường tự khỏi mà không cần điều trị. Tuy nhiên, những người bị suy giảm miễn dịch hoặc có vấn đề sức khỏe tiềm ẩn có thể cần dùng kháng sinh để loại bỏ vi khuẩn.
Dùng kháng sinh trên bệnh nhân khỏe mạnh thực sự có thể gây ra tình trạng ứ đọng vi khuẩn salmonella, dẫn đến nhiễm trùng lan rộng hơn hoặc nhiễm trùng mạn tính.
Một tổng quan Cochrane năm 2000 cho thấy những bệnh nhân sử dụng phác đồ kháng sinh có kết quả âm tính trong tuần điều trị đầu tiên, nhưng tái phát cũng thường xuyên hơn. Một tổng quan tiếp theo về phương pháp điều trị salmonella cho thấy một số bệnh nhân báo cáo các triệu chứng trở nên tồi tệ hơn sau khi điều trị bằng kháng sinh.

Một nghiên cứu khác năm 2016 theo dõi 1,047 bệnh nhân bị nhiễm khuẩn salmonella dai dẳng cho thấy hơn 90% có hệ miễn dịch bình thường và những người điều trị bằng kháng sinh có tỷ lệ bị nhiễm trùng dai dẳng cao gấp ba lần.
Tiến sĩ Elizabeth Hohmann, bác sĩ bệnh truyền nhiễm tại Bệnh viện Đa khoa Massachusetts, nghiên cứu tập trung vào nhiễm trùng đường tiêu hóa và hệ vi sinh vật đường ruột, nói với The Epoch Times: “Từ lâu, chúng ta đã biết rằng việc điều trị cho những người không bị bệnh [bằng kháng sinh] thực sự có thể làm giảm lưu thông trong ruột và làm chậm quá trình đào thải vi khuẩn salmonella.”
Một số nghiên cứu cho rằng sự tồn tại dai dẳng của vi khuẩn salmonella có thể là do vi khuẩn nằm im trong ruột. Tiến sĩ Hohmann cho biết, nguyên nhân cũng có thể là do thuốc kháng sinh làm tổn hại đến lợi khuẩn đường ruột.
Cô nói thêm rằng nếu có các triệu chứng nhẹ, không phải trẻ em hay người già, không kèm theo nhiều bệnh lý hoặc đeo thiết bị giả và đang khỏe hơn, thì thông thường, không nên điều trị.

Hoa Kỳ kiểm soát Salmonella như thế nào?
Bất kể việc thường xuyên có thông báo về việc thu hồi thực phẩm nhiễm Salmonella để đẩy mạnh nhận thức về sự bùng phát Salmonella đang lưu hành, các chuyên gia an toàn thực phẩm cho rằng Hoa Kỳ đang làm khá tốt trong việc kiểm soát các trường hợp nhiễm trùng.
Tỷ lệ nhiễm Salmonella trung bình là khoảng 15 trên 100,000 ở Hoa Kỳ. Liên minh Âu Châu năm 2021 có tỷ lệ công bố là 15.7 trên 100,000.
Năm 2021, Úc đã báo cáo tỷ lệ công bố là 42 trường hợp trên 100,000 người. Canada đã báo cáo tỷ lệ mắc hàng năm là 19.7 trên 100,000 trong năm 2019.
Một số quốc gia, như Nhật Bản và Thụy Điển, có tỷ lệ nhiễm trùng salmonella rất thấp. Nhật Bản đã báo cáo 2.4 trường hợp trên 100,000 người trong năm 2011, trong khi Thụy Điển có tỷ lệ mắc là 6.3 trên 100,000 vào năm 2022.
Ông Fouladkhah cho biết so sánh Hoa Kỳ với các quốc gia phát triển khác nhưng nhỏ hơn này sẽ không công bằng. “[Ở Hoa Kỳ] có sự khác biệt lớn giữa các tiểu bang, giữa các cơ sở lớn và nhỏ.”
Ông De Mello quy sự khác biệt cho thuốc kháng vi sinh vật được sử dụng trong quy trình chế biến thực phẩm. Ví dụ, thông thường, Hoa Kỳ là làm sạch thịt bằng chlorine và các chất khử trùng khác. Âu Châu đã cấm điều này vào năm 1997 do lo ngại rằng các hóa chất có thể được sử dụng để khỏa lấp cho các hành vi vệ sinh kém và các vấn đề an toàn cho động vật.
Hoa Kỳ cũng sử dụng thể thực khuẩn, virus diệt vi khuẩn, trong chế biến thịt. Nghiên cứu của ông De Mello, được công bố trên Meat Science, đã cho thấy rằng thể thực khuẩn làm giảm 90% Salmonella trong thịt.
Tuy nhiên, đó vẫn là một can thiệp tương đối thích hợp.